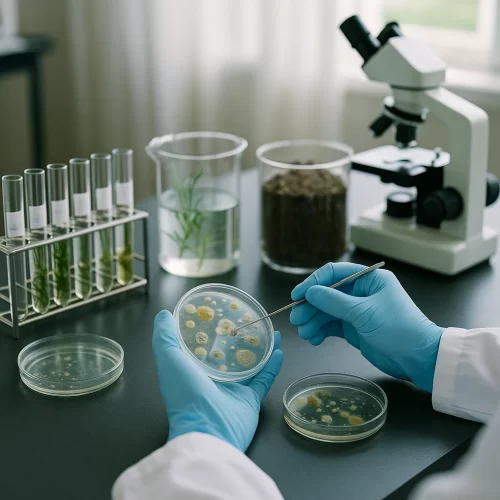
id-natura-Testes Ambientais e Testes de Microbiomas

Testes Ambientais e Testes de Microbiomas
Pode ser necessário testar concentração micro esporos de fungos ambientais, concentrações de asbestos, VOCs e outros contaminantes ambientais sejam eles físicos ou químicos.
Estudos de perfis de microbiota intestinal ou de outros órgãos também podem ser feitos na ID.Natura; temos as melhores parcerias para este efeito.
Estudos geobiológicos de subsolo também podem ser necessários (após identificação distúrbios de origem geopatogénica). Podem ser indicados outros testes laboratoriais médicos ambientais ou a avaliação dos espaços habitacionais por especialistas.
Quando necessários, estes testes podem ser feitos nos nossos parceiros ou em local/empresa à escolha do paciente.